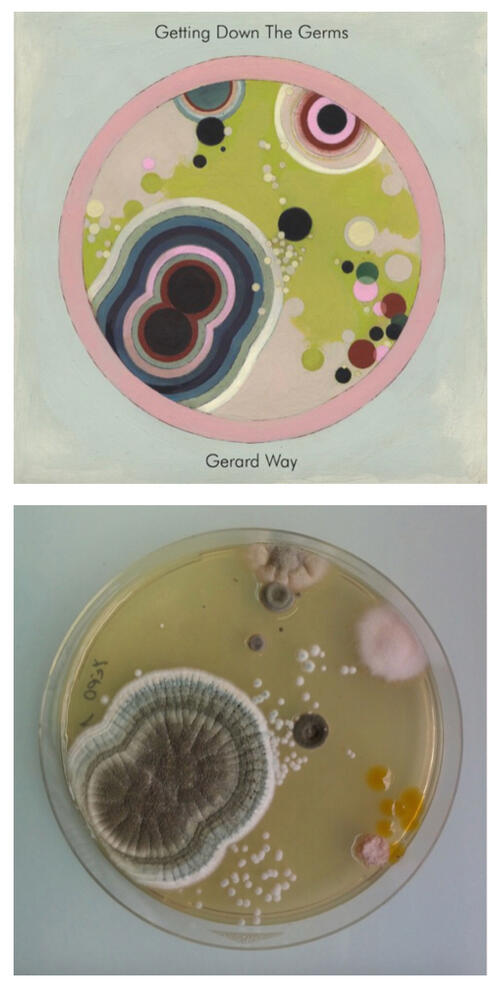

“and so he gets to die a saint, but she will always be a whore”
aka: lindsey way and double standards in the mcr fandom

TW for discussions of p.dophilia, sa, racism, abuse (terms censored as carrd wouldn’t let the site be published when they weren’t)
(best viewed in widescreen)DISCLAIMER: lindsey is not a 100% unproblematic queen who’s never done anything wrong, please do not misconstrue any of this as saying she’s a perfect flawless person. but there’s a lot of misinformation spread about her, and the fandom’s treatment of her wrongdoings in comparison to the members of mcr is extremely hypocritical, immature, and frankly stems from misogyny. criticizing lindsey doesn’t make you misogynistic, but the culture in the mcr fandom surrounding her in comparison to how people treat the members of mcr is rooted in misogyny.SECOND DISCLAIMER: the aim also is not to “cancel” any of mcr, this was created by and for mcr fans as a response to the fandom’s treatment of this woman and situations involving her. but mcr, like lindsey, are not perfect people, and have made many mistakes over the years, and definitely get special treatment in comparison to how fans treat lindsey.FINAL DISCLAIMER: this is sort of a forever work in progress, when new information is found that seems important (on either “side”) it’s added. if you have constructive criticism, or anything you feel should be changed/added, please message @lindseywaymisinfo on tumblr.this is mostly going to serve as a sort of “masterdoc” debunking common misinformation and misconceptions that are spread about lindsey. but before getting into that, i feel the need to explain that for a while i was also convinced of the whole “lindsey is a horrible irredeemable person” narrative. that was until i decided to look into things myself and not just take people on the internet’s word for it (if most of your information on why someone is a bad person is coming from an account called something like “lindsey way ugly liar” you should probably realize they have a bit of a bias). i also had to unpack the parasocial aspect of being compelled to defend the mcr members or write off their mistakes as “not that big of a deal”, while simultaneously disliking lindsey for similar situations.something to consider before getting into the “debunking”:lindsey has been receiving mass hate/harassment from gerard/mcr fans since long before any of her alleged problematic acts even occurred. the hate against her originally stemmed from zero reason other than the fact she was married to gerard way. below are just a few of many comments from 2007-2013. two out of the six comments shown even specify that they ‘don’t know why’ they hate her. people have been looking for reasons to justify their hatred for almost 2 decades.

now also consider:
why do you hate lindsey for not addressing the accusations of a former friend and collaborator (jimmy), while loving gerard who also didn’t address the accusations of his former friend and collaborator (having made a song with jimmy as recently as 2018)? why do you have no issue with mikey way dating a teenage fan (not a minor, still a teenager) while in his 30s? mcr’s negative actions don’t make lindsey’s better, but if you are intent on “holding lindsey accountable”, you should feel the same about mcr.most importantly: if lindsey truly is so horrible, why do you continue to support gerard, who in that case would be complicit due to their constant declarations of love and support of her?now onto the main points- - -1. "lindsey defended jimmy urine”
if you see someone say this, the assumption is that when the allegations came out about jimmy in 2021, lindsey defended him or said they were untrue. i know that’s what i originally assumed. this is the screenshot in question where she “defends him”:

lindsey way hasn’t used twitter since 2020. the allegations against jimmy urine came out mid-2021. aka, this exchange is NOT about the p.dophilic sa accusations of jimmy, this is about him kissing fans at shows and never checking whether or not they were legal. that is still gross. but that is nowhere near the same as her defending him against a legitimate legal accusation of sexual relations with a minor.some further context is that this tweet was directed at her during one of the main periods of time where people were mass harassing her due to rumors being started by jessicka addams (who will be discussed more in later sections), providing some context to her hostile response. her reply is still very immature and not at all thought-out and she should’ve taken a moment to regulate her emotions before responding to something so potentially serious, but if you take a moment to attempt seeing her side of things (having someone you once trusted spread lies about you causing harassment to come your way) it isn’t too hard to understand why she would jump to this response.something else to note about this situation is that this exchange has since been deleted. technically we don’t know why, but it seems logical to assume that lindsey later realized it wasn’t a mature way of handling things, and that the situation wasn't what she thought it was.saying someone is a p.dophile defender is an extremely strong claim to make about a person, let alone saying they are a p.dophile. that tweet, while immature and not at all thought out, is not defending pedophilia. i’ve seen many exchanges along the lines of someone asking “hey i’m a new fan, what's the deal with lindsey? why is she problematic?” and someone replying “oh she's a p.do”. i feel like it should be common sense that that is a horrible thing to casually call someone with no proof.not only has lindsey previously gone out of her way to find and post resources on how to spot and stop things like grooming, she has also opened up about how she personally is a victim of sa, which was possibly even p.dopholic, which makes the false narrative spread that she is a r.pe/p.dophilia defender especially sick.



(the tweet in dark mode has since been deleted, and i hesitated about including it, but felt that it was important for people to know)some still argue that lindsey endorsed jimmy simply by not saying anything on the situation. if you stand by this stance, then you should treat gerard the same way due to multiple of their friends and collaborators (jimmy, scott allie, neil gaiman…) ending up with sa allegations, none of which gerard addressed.
- - -2. “lindsey blocked fans who asked her to speak out about blm”
lindsey posted/reposted multiple resources and discussions about blm, how to help the cause, and how to educate yourself (a quick trip to her twitter will prove this due to it being her most recent tweets). when fans asked her to repost things, she would. (first image is her personal postings about acknowledging her privilege as a white person). when a black fan told her that her ‘black out tuesday’ post seemed performative, lindsey replied, sympathizing, agreeing, and asking for any resources they’d prefer she post (second image).


in june, the twitter user below was one of many who asked lindsey (and gerard) to use her platform for the cause. lindsey liked and retweeted these tweets.


when you hear “lindsey blocked a fan who asked her to discuss blm”, you assume they mean that the fan asked her and then she blocked them instead of acknowledging it, once again this is what i originally assumed. this isn’t the case, she positively interacted with the tweets. she later blocked the user in november, half a year after the events. the question of “why?” does still remain, but if her reasoning was to silence people asking her to speak up about blm… why would she silently block them 6 months after the whole thing happened? what would she gain from that?what seems like the most likely reason of why she blocked them (in my opinion, this is not fact) is that after interacting with so many of this person’s posts, she kept getting this random fan on her feed, so she blocked them not thinking they’d notice/care. we should also remember that at the time lindsey was 45 years old, the way she maneuvers her social media isn’t going to be the same as chronically online gen-z. when gerard, who’s around lindsey’s age, used twitter, they would block people pretty often. there were even multiple times gerard blocked fans on accident (image below is one of these times), which very likely could’ve been what happened with lindsey here.

lindsey posted more about blm than gerard, frank, and mikey combined. a quick look at her twitter will also show you that when she used it she would often repost other resources, such as organizations to help women and lgbtq+ people in need.
- - -3. “lindsey’s a race faker, she claims she’s indian”

one time, over a decade ago, she tweeted that she was indian (as well as french). a quick look at the day of this tweet shows the further context of her explaining that her grandmother is from india.considering the fact that there have since been multiple examples of her clearly knowing and saying she’s white, one being in section 2 above, she clearly isn’t actually trying to convince anyone that she’s not a white woman. the further context of the statement being “i’m french and indian” makes it seem clear to me that she was just explaining nationalities she technically has in her bloodline. she isn’t a “racebaiter”, she’s just like that one annoying gen x white woman teacher you had in middle school who found out she was 5% native american on ancestry.com and proceeded to tell everyone that she’s part cherokee. you’re allowed to think lindsey’s annoying or out of touch or weird for this, but using this to tell people with no further context that she’s racist is unfounded.(something to note generally, though, is that many kashmiri people do not identify as indian)-3.5. “lindsey lied about being adopted”
in this screenshot she also says that she’s adopted, which her estranged family has said is false. similar to the indian comment, though, this seems to be the only time she has said this. “ballato” is an italian surname, explaining why she’s saying people assume she’s italian. lindsey’s sister has explained that their birth last name is “boyer”, but it was eventually changed to “ballato” for their mother’s third husband. it seems likely to me that her explaining the name situation as “i was adopted” was just a quick explanation to avoid getting into the more complicated, “messy”, nature of the name change. this especially makes sense alongside the fact that she never discussed being “adopted” any other time.-something interesting to also note in relation to the indian part, is that around 6 months after lindsey tweeted that, gerard tweeted about how he’s actually spanish. he said it again 2 months later. none of his family (including his fellow famous brother mikey) have ever mentioned being spanish, yet i have never seen gerard be ”called out” for this. due to the closeness of the pair’s tweets, my personal theory is that they both took some sort of dna test (ancestry.com, etc) and got surprising results.

- - -4. “lindsey slept with a married man”
this is a rumor. if we believed every single rumor, most of mcr would be in trouble. this is also specifically a rumor started by jessicka, who is proven to be an unreliable source (again: more elaboration later).the only “proof” of this affair is an art piece from her “sh.tty teen” showcase. the collection made art out of notes she wrote and received during her teenage years, which is why it’s titled sh.tty teen. one of these notes was from a boy who likely had a crush on her, and he mentions another boy named jimmy. he also mentions lindsey ignoring him “in the hallways”. this note was taken out of the collection’s context and framed as being from her bandmate steve righ, the “jimmy” mentioned being jimmy urine. in a showcase of notes from her teenage years, i don’t see why she’d include one note from her adulthood. it’s also confusing to imagine two adults who live in the same tour bus passing each other notes, specifically notes that discuss their interactions “in the hallways”. on the chance this note truly was from righ, though... nothing within it indicates hooking up.i can’t 100% say for certain this affair didn’t occur. while there’s no irrefutable evidence it happened, there technically isn’t any evidence it didn’t. but if it did happen, it was decades ago, and she’s now been in a steady relationship for the past 17 years. i fail to see how this would be “cancel-worthy”, but the possibility of gerard cheating on his ex-girlfriend with bert mccracken is just a silly fandom anecdote, and the even more likely possibility that he cheated on said girlfriend with eliza cuts is completely ignored.i once again will reiterate: the purpose of all this isn’t to prove lindsey is perfect, or to convince you to “stan” her. it is to debunk misinformation, and to confront the double standards of how the mcr fandom treats situations like this.

- - -5. “lindsey created nowaymikeyway”
once again a rumor. and if it is true, while definitely an immature thing to do… why is this such a bad thing? this would mean that she thought a famous man was mistreating a woman, a woman who was her friend, and she decided to call him out on it even if she knew it would be controversial with the public and with her spouse. i’m aware that mikey likely did not cheat, but at the time, most people (including fans) were convinced he did. male rockstars taking advantage of women is something that mcr, especially gerard, have always been vocally against. if lindsey thought this was happening, why would her calling it out be so horrible?and most importantly, her and mikey clearly get along. they follow each other on every platform, interacted with each other on social media many times when lindsey still used it, mikey’s wife kristin also often positively interacted with her. i do not think that lindsey was behind the blog, but on the off-chance that she was, clearly her and mikey have worked things out and there’s no bad blood. if mikey has forgiven her, who are you defending?
- - -6. “she cut off her family and called them toxic/abusive”
i fail to see why cutting off an abusive family for your mental well-being would be seen as problematic.people’s argument against lindsey here is that her family claims she lied about them being toxic. but what kind of person would openly step up to say that they abused someone? it’s entirely possible that they just wanted to save face. and while it’s also technically possible that lindsey could be lying, i’d rather believe someone claiming to be a victim and end up being wrong, than attack someone who ends up being a victim. and as a tweet in section 1 explains, lindsey claims that she was sa’d and her family took the perpetrator’s side, her mother staying in a relationship with the individual. in this particular situation, it’s very doubtful that her family would openly admit to being in the wrong.
- - -7. “she plagiarizes art”
in terms of the ‘getting down the germs’ cover artwork… this one’s true. i’m not going to make up a lie to convince you it’s not. i’m here to try explaining the truth behind things, not blindly defend a woman i’ve never met from any possible negativity.

the top image is the germs cover, and the bottom is a piece by the artist antoine bridier-nahmias. as an artist, this hurts to see. the idea of making a piece and it then being copied by someone with a larger platform, and then used as cover art for someone with an even larger audience is extremely upsetting.in this situation though, i do think it’s important to keep in mind lindsey’s style of art. in response to the germs controversy, many have tried claiming other art of hers/all of her art is stolen/plagiarized. if you look at lindsey’s art, she clearly gravitates towards a style inspired by artistic appropriation, a very real post-modern artistic style/method which involves recreating or modifying pre-existing art or images. in recent years it has become a more controversial type of art due to the rise of young artists raised to instinctively defend art against being plagiarized or stolen. below are a few other examples of lindsey's art and what they're referencing/recreating. i highly doubt she would claim she originated that alice in wonderland illustration, if asked about it she would likely explain it was a recreation of the original.




there’s also a chance that when choosing a reference image, lindsey mistook the sculpture for a real photo. this is not an attempt to make excuses for her, but to genuinely consider all possible explanations.it’s an interesting topic of discussion art-wise to try and decide when things stop simply being artistic appropriation and start to be plagiarism. in my opinion that line is crossed when the work being recreated/referenced isn’t very well known + is created by a still active artist and isn’t credited.basically, lindsey was wrong in the germs artwork incident, but i think the situation is a bit more nuanced than just “she stole someone’s art”, and i don’t think this specific instance immediately discredits all the art she’s ever made in her life, or her integrity as a person.
- - -8. “she was in msi, that in itself means she’s horrible and irredeemable”
jimmy is horrible. looking back on some of their lyrics, they were horrible. but, and i know this phrase usually raises red flags, it was a different time. i don’t mean that as in “racism was fine!”, i mean that what many people now don’t realize is that at the time, in their own weird way, msi were considered progessive.a video i highly recommend, which discusses this topic better than i can, is the youtube video "what happened to mindless self indulgence?" by 'common revolt'. the video is only 8 minutes long and explains things in an understandable and sensible manner.another resource linked below is a post made by a queer person who was a fan of msi while they were active and it describes what i’m trying to explain much more eloquently, in more depth, and with needed nuance on the topic, acknowledging that they weren't perfect by any means. though, this post was created before the allegations of jimmy urine came to light.
tldr: whether or not you think they succeeded in their goal (i don’t), msi’s controversial lyrics were intended to be controversial for "irony" and to make a statement. many people like to forget that the way gerard and lindsey met is due to playing the same shows, and mcr being fans of msi. years before they were on projekt revolution together, mcr opened for msi in 2003. gerard claims to have loved msi since the 1990s. mikey would sometimes wear msi merch onstage during mcr shows. msi members featured on the danger days album, were in the music videos, and even appeared onstage in-character. even after mcr ended, frank went on to tour with msi with his group death spells. due to mcr’s outwardly progressive views throughout their career, looking back it may seem to make no sense why they’d support/befriend a band like msi if you don’t consider the context of the time.i feel the need to clarify, i personally hate msi and actively avoid msi content. i am in no way trying to “defend” msi, simply trying to explain that it wasn’t just a group of raging bigots. in fact, the members were largely politically liberal. they were clumsily saying offensive and insensitive things in an “ironic” way, as a “statement”.something that i feel like many gloss over specifically on the topic of jimmy in relation to lindsey, is that jimmy’s accusations are legally said to have occurred from 1997-1999. lindsey didn’t join msi until 2001.something else i think is important to bring up in relation to jimmy, but i can very easily see being taken the wrong way so i will clarify again: i hate jimmy. i personally believe him guilty of his accusations due to my stance of believing possible victims first. but for full transparency, there technically is a chance he is innocent. his case was dismissed permanently and settled out of court. aka, he was not legally found guilty or innocent.it’s also worth noting that lindsey no longer goes by her msi stage name, “lyn-z”. the main example of this is how her instagram, which is her most recently used platform, only uses “lindsey”. nowadays she’s clearly focused pretty much solely on her visual art. and while her bio does specify that she’s a “visual artist and a bass player”, there’s no specific mention of msi. as stated in the video i recommended, msi announced a hiatus in 2014, which never ended. the members all went on to do different things with their lives, lindsey focusing on her family and visual art.

another example of her lack of "lyn-z"; on the mcr return tour when gerard wore their unicorn shirt with lindsey’s name on it, it wasn’t the original which read “lyn-z”, it was a new version of the shirt which instead says “lindsey”.

9. pretty much anything else: speculation, misinformation and rumors that stem from random teenagers online or known liars.
a big example is that despite actively seeking it out, i have yet to find any proof of lindsey doxxing anybody ever, despite this being one of the reasons people give when asked why they don’t like lindsey / why she’s problematic. many other random claims can be easily disproven by looking at things her and gerard have actually said and posted.“known liars” in the heading of this section refers to jessicka, former friend of lindsey’s (and gerard’s). the two had a falling out, and jessicka took to social media to discuss how horrible lindsey is, as well as gerard. i personally do not find jessicka a reliable source due to the fact multiple things she’s said have been proven false, and she is a p.dophilic sa perpetrator. though, if we did believe everything she says about lindsey, this would also mean we should believe everything she’s said about gerard. jessicka has called gerard a fake feminist who secretly abuses lindsey. purposely cherry-picking things she’s said about lindsey and claiming they’re true, while ignoring the claims about gerard, is disingenuous and biased.i reached the limit of what you can include in a site without paying money, so if you want more information/evidence on the jessicka situation go to jessickaproof.carrd.cothe charlie situation was a fandom controversy in the early 2010s that i won't be getting too into due to a severe lack of concrete proof/evidence + the fact that charlie herself has expressed wanting people to stop bringing it up. this situation is something some try to use against lindsey. the sad truth of that matter is we will never truly know the entire story of what happened, due to the fact it happened mostly in person, and none of us were there. multiple different people have claimed to be former friends of charlie so they know what happened. i've seen one of these people say lindsey treated her poorly, while i've seen two or three others say lindsey didn't do anything out of the ordinary. there was a cyber-aspect of the situation, which charlie herself said lindsey had no part of and was orchestrated by jessicka and chantal claret. the only person to claim lindsey was part of that, was jessicka (and then by association, lucinda, a friend of hers, who claimed jessicka had no part of it. there is legitimate photographic proof for jessicka's involvement, none for lindsey's). in 2020, almost a decade after the situation, charlie still stood by the claim that it was solely jessicka and chantal, though mostly jessicka. there is no proof to suggest otherwise, so i do not see why anyone would choose not to believe the actual person affected. similar to the nowaymikeyway situation, i can't help but think it has more to do with looking for reasons to hate lindsey than it actually has to do with caring about the person who would've been negatively affected, as both charlie and especially mikey seem to have no ill will towards lindsey.
- - -this doesn't really fit into a specific section, but i feel the need to further discuss the double standard in how the fandom treats lindsey vs mcr. gerard pretty much had the same level of closeness to jimmy urine as lindsey, calling him a best friend, incorporating him into multiple pieces of mcr content, and collaborating with him on music (more recently than lindsey in fact). there's also multiple unsavory depictions of minorities in early umbrella academy comics. mikey dated a 19 year old fan when he was in his 30s, and is currently married to a trump supporter. frank had a hate symbol tattooed on his body for over a decade and has multiple sexist old tweets. i could go on but i won’t because this isn’t meant to be a competition of who’s more or less problematic, or a “gotcha!” moment, i love the mcr guys. it’s just very frustrating that if lindsey had done any of those things, you’d never hear the end of it. lindsey, who’s openly discussed being a queer woman and having dated multiple women, gets called a queerbaiter for misremembering what a shirt she wore over a decade prior said, while a clip of frank iero, who openly identifies as straight to this day (in his blm post from 2020, which you can find on his instagram, he refers to himself as a straight white man), saying the f slur still gets reposted as a silly clip that people love. i am not saying that frank should be “cancelled” for saying it, i understand the reasons for doing so, i am just pointing out the hypocrisy in the fandom’s treatment of these situations.
- - -final point: you can’t separate lindsey from mcr.
you can personally hate lindsey for whatever reason, you can choose not to post about her or avoid posts including her, you can think she’s problematic. that’s your prerogative. you are not obligated to like her. but if you’re an mcr fan, especially a gerard fan, and harass others for posting about lindsey, you are extremely hypocritical. if talking about lindsey at all in a positive light is problematic, i have some bad news about gerard. every other member of mcr also follows lindsey social media and positively interacts with her offline.summertime is a song about lindsey. the world is ugly is a song about lindsey. “the aftermath is secondary” is a quote from lindsey. drugstore perfume’s title came from lindsey. the character party poison wears lindsey’s tie around their wrist. if you go to an mcr concert there is a decent chance gerard will mention lindsey onstage. there is even a chance they will perform in a shirt with her name painted on it.if you get mad at people for posting about lindsey, meanwhile you consistently post about her spouse of almost two decades who constantly talks about how amazing she is and how much he loves her, you are at a high level of hypocrisy. gerard is almost 50 years old. they're not a poor baby who's too innocent to see that their wife is actually a horrible evil witch. they very outwardly love and support her to an extreme degree. if lindsey really was as horrible as many make her out to be, gerard would be complicit.
- - -TLDR: i don’t think lindsey is 100% unproblematic. she’s technically stolen/plagiarized art, she often acts before thinking, resulting in immature responses to criticism, and was a complicit bystander of inappropriate onstage behavior of her bandmate. but it makes no sense to act like she’s satan incarnate, but simultaneously post about people who have also done problematic things, are friends with her, and one of which has been married to her for almost 20 years and has a child with her. in all, lindsey isn’t perfect, but she isn’t a monster. same as gerard, mikey, frank, and ray.
